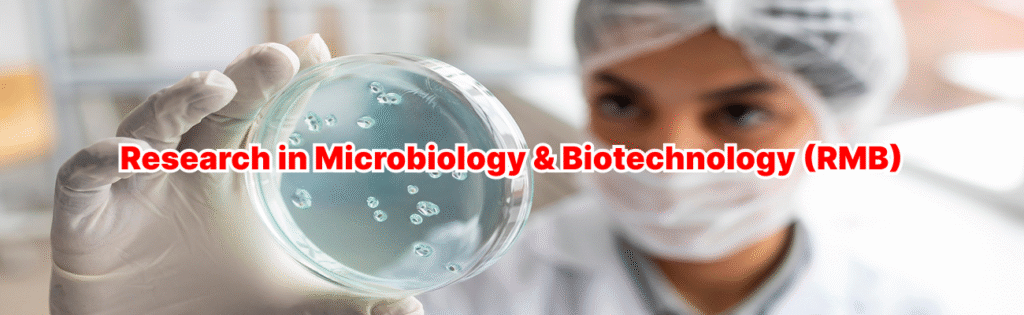

Research in Microbiology and Biotechnology (RMB)
Journal Cite Score: -
Journal Impact Factor: -
Average acceptance to publication time: 7-25 days
Average article processing time: 10-20 days
Journal H-Index: -
Please submit article at publish@probejournals.com
Research in Microbiology and Biotechnology (RMB) is a peer-reviewed, international scholarly journal dedicated to publishing high-quality original research, reviews, and short communications across all areas of microbiology and biotechnology. The journal aims to serve as a platform for scientists, academicians, clinicians, and industry professionals to disseminate novel findings that advance fundamental knowledge and applied innovations involving microorganisms and biotechnological processes.
RMB covers a broad spectrum of topics including, but not limited to, microbial physiology and genetics, molecular and cellular microbiology, medical and clinical microbiology, environmental and agricultural microbiology, industrial and food microbiology, microbial biotechnology, bioprocess engineering, bioinformatics, genomics, proteomics, and emerging biotechnological applications. The journal particularly encourages interdisciplinary studies that bridge microbiology with biotechnology, nanotechnology, bioengineering, and environmental sciences.
The journal is committed to maintaining high ethical standards, rigorous peer review, and timely publication. By promoting open scientific communication, RMB seeks to support global research collaboration and contribute to scientific progress and societal benefit.
Aim and scope
Research in Microbiology and Biotechnology (RMB) aims to publish high-quality, peer-reviewed research that advances fundamental and applied knowledge in the fields of microbiology and biotechnology. The journal serves as an international platform for researchers, academicians, clinicians, and industry professionals to share innovative scientific findings related to microorganisms and biotechnological applications that contribute to scientific progress, public health, environmental sustainability, and industrial development.
The journal welcomes original research articles, reviews, mini-reviews, and short communications that address theoretical, experimental, and applied aspects of microbiology and biotechnology etc. Special emphasis is placed on interdisciplinary studies that integrate microbiology with molecular biology, bioengineering, environmental sciences, agriculture, medicine, and industrial processes.
Microbiology
- Bacteriology, virology, mycology, and parasitology
- Medical and clinical microbiology
- Environmental and agricultural microbiology
- Microbial ecology and diversity
- Microbial physiology, metabolism, and genetics
- Molecular and cellular microbiology
- Antimicrobial resistance and pathogenesis
- Microbial biofilms and host–microbe interactions
Biotechnology
- Microbial biotechnology and industrial microbiology
- Bioprocess engineering and fermentation technology
- Genetic engineering and recombinant DNA technology
- Enzyme technology and biocatalysis
- Agricultural and food biotechnology
- Environmental biotechnology and bioremediation
- Medical and pharmaceutical biotechnology
- Bioinformatics, genomics, proteomics, and metabolomics
- Nanobiotechnology and synthetic biology
Article Types Accepted
RMB considers the following manuscript types:
- Original Research Articles
- Systematic Reviews & Meta-Analyses
- Narrative Reviews & Mini-Reviews
- Clinical Trials
- Short Communications
- Case Reports / Case Series
- Perspectives & Commentaries
- Methodology Papers
- Editorials (by invitation) etc.
Privacy Statement
The names and email addresses entered in this journal site will be used exclusively for the stated purposes of this journal and will not be made available for any other purpose or to any other party.
OA articles count: 52
OA journals count: 11
Journals By Subject
Clinical Sciences
Medical Sciences
General Sciences
Engineering Journals
Article Statistics
Accepted
Article
(28.41%)
Rejected
Article
(40.89%)
Submitted
Article
(30.09%)
Associated and indexed with












Editorial Board
Our Editors
The editorial board members will be announced soon.
Author Guidelines
General Requirements
- Manuscripts must be original, unpublished, and not under consideration elsewhere.
- All submissions must comply with ethical standards (ICMJE, COPE).
- Clinical studies must include ethical approval and informed consent.
- Clinical trials should be registered in a recognized registry.
Research in Microbiology and Biotechnology (RMB) is a peer-reviewed, international scholarly journal dedicated to publishing high-quality articles across all areas of microbiology and biotechnology.
Authors are invited to submit original research papers, review articles, case studies, and technical notes etc. to Research in Microbiology and Biotechnology. All submissions must be original, unpublished, and not under consideration elsewhere.
The journal welcomes direct submissions of manuscripts from authors. You can submit article at publish@probejournals.com
After submitting articles, authors will get all regular updates of the articles. Updates will include preliminary quality analysis, reviewer process, editor decision, publishing of the article etc. Galley proof will be done in standard formats, followed by preparation of pdf, full text etc. Accepted articles will be published within 20-25 days.
Article Processing Charges (APC)
Our journals are not receiving any kind of financial support. The journal not charging any kind of subscription/submission fee, but we charge the fee.
For all kind of articles, the Article Processing Charges (APC) would be EUR 1019.
Author Withdrawal Policy
We are not charging any kind of withdrawal fee if the authors want to withdraw the article within 3-5 days. If the authors want to withdraw the article after 5 days, we will charge EUR 319 as a withdrawal fee.
General Instructions
Covering Letter: All submissions must include a covering letter specifying the manuscript type (e.g., Research Article, Review Article, Brief Report, Case Study, etc.). Authors may not categorize submissions as Editorials, Letters to the Editor, or Concise Communications unless specifically invited by the editorial office.
Authorship Compliance: Ensure that all listed authors meet the journal’s authorship criteria as outlined by Journal.
Exclusivity: Manuscripts must not be under review or consideration by any other journal at the time of submission.
Conflict of Interest & Financial Disclosure: Clearly disclose any financial support from commercial sources or other potential conflicts of interest. Any competing interests should also be addressed upon publication.
Title Page Requirements:
Include a clear title and detailed author information on the title page.
Author details should include:
- Full Name
- Institutional affiliation
- Academic qualifications
- Contact information
The corresponding author must provide a complete mailing address, telephone number, fax number, and email address.
Manuscript Formatting:
Paginate all pages sequentially, including references, tables, and figure legends.
Page 1 should be the title page, including:
- Short running title (no acronyms)
- Full title
- Authors’ names and academic degrees
- Funding acknowledgments
- Contact details for correspondence and reprint requests
Manuscript Categories & Guidelines
1. Research Articles
Based on original empirical or secondary data using a defined research methodology.
Must contribute new knowledge to the field of journal.
Include a minimum 300-word abstract structured into: Objective, Methods, Results, and Conclusion, with 7–10 keywords.
Structure:
- Introduction
- Literature Review
- Methodology
- Results & Discussion
- Conclusion
- References, Tables, and Figure Legends
2. Review Articles
Based on secondary data relevant to the journal’s scope.
Provide a critical overview of a specific topic.
Include:
- 300-word abstract
- Relevant keywords
- Introduction to the topic
- Analytical discussion with appropriate visual aids
- Summary and conclusion
- Full references
3. Commentaries
Brief opinion pieces by subject matter experts discussing current advancements or developments.
Include:
- Title and abstract with keywords
- Direct analysis of the issue with optional figures/tables
- Conclusion and references
4. Case Studies
Present detailed reports of individual cases that provide new insights in topic Format:
- Cases and Methods section (describing the clinical issue and approach)
- Discussion
- Conclusion
5. Editorials
Short commentaries on recently published research or journal issues.
- Only accepted upon invitation from the editorial office.
- Must be submitted within three weeks of the invitation.
6. Letters to the Editor / Concise Communications
Commentaries on previously published articles.
- Must be concise and directly address issues or findings presented in the original article.
- No abstract or subheadings required.
- Should be submitted within six months of the article’s publication.
Copyrights
The journal retains the copyright and any extensions or renewals thereof worldwide. This includes, but is not limited to, the rights to publish, disseminate, transmit, store, translate, distribute, sell, republish, and use the contribution and its contents in both print and electronic formats, as well as in derivative works. These rights apply across all languages and media formats, now known or developed in the future. The journal also reserves the right to license or permit others to exercise these rights.
Publication Ethics and Malpractice Guidelines
Responsibilities of the editors
This Journal is always a collaborative effort. Managing challenges of research integrity and publishing ethics in journal is no exception. Legal concerns may arise as a result of these issues. We recommend that journal use these principles as a starting point for developing policies and processes, as well as when dealing with problems.
We recommend that editors, publishers, and other journal team members discuss the concerns raised as a first step in addressing any issue. We recommend that these discussions take place before taking any further action, and that legal advice be obtained if necessary, especially when matters involve potential defamation, violation of contract, privacy, or copyright infringement.
Confidentiality
The corresponding author, reviewers, potential reviewers, other editorial advisers, and the publisher, as appropriate, are the only people who should know about a manuscript that has been submitted to them.
Responsibilities of reviewers
The peer-reviewing process helps the editor and editorial board make editorial judgments, and it may also help the author improve their manuscript. Any referee who feels unqualified to examine the research described in a paper or understands that timely review is impossible should inform the editor and withdraw from the review process. Manuscripts submitted for review must be treated as private papers. They must not be shared or discussed with anyone else unless the editor has given permission.
Review Process
Our journal follows double blind peer review process. Initially preliminary analysis will be done for all type of articles, later editors will check the scope of the articles, followed by the review process. Editor’s decision will be the final step to accept the articles.
Submit Manuscript
Research in Microbiology and Biotechnology (RMB) is a peer-reviewed, international scholarly journal dedicated to publishing high-quality original research, reviews, and short communications across all areas of microbiology and biotechnology. The journal aims to serve as a platform for scientists, academicians, clinicians, and industry professionals to disseminate novel findings that advance fundamental knowledge and applied innovations involving microorganisms and biotechnological processes.
Authors are invited to submit original research papers, review articles, case studies, and technical notes etc. to Research in Microbiology and Biotechnology. All submissions must be original, unpublished, and not under consideration elsewhere.
Submit manuscript at Online Submission System or send as an e-mail attachment to the Editorial Office at publish@probejournals.com
After submitting articles, authors will get all regular updates of the articles. Updates will include preliminary quality analysis, reviewer process, editor decision, publishing of the article etc. Galley proof will be done in standard formats, followed by preparation of pdf, full text etc.
Accepted articles will be published approximately in 20 days.
Journal Archives
Coming Soon
Archived volumes will be available here soon.
Articles in Press
Coming Soon
This section will contain articles that have been accepted and are awaiting final publication.
Contact
Registered Address:
91 Ivy Lane, Waltham Cros, United Kingdom, EN8
Address:
Probe Publisher, 45 Highfield Road LONDON, UK
Email:
publish@probejournals.com
Phone:
+44 3455007136

